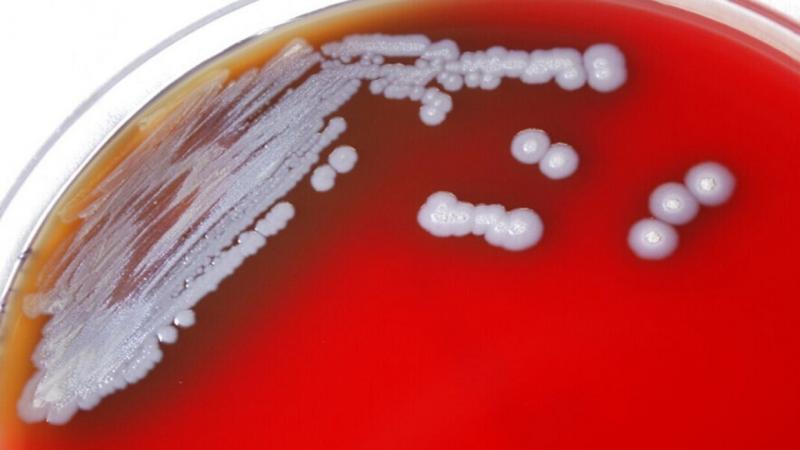
خبير يدق ناقوس الخطر بشأن بكتيريا خطيرة

خبير يدق ناقوس الخطر بشأن بكتيريا خطيرة
أعلن غريغوري وينتر، الأستاذ بجامعة كامبريدج والحائز على جائزة نوبل في الكيمياء، أن مواجهة ما يسمى بالميكروبات المرآة قد تكون مستحيلة إذا غادرت المختبرات.
ويشير إلى أن العديد من الجزيئات الأساسية للحياة يمكن أن تتواجد في شكلين مختلفين، كل منهما مرآة للآخر.
ووفقا له، يتكون الحمض النووي لجميع الكائنات الحية من النيوكليوتيدات "يمنى"، والبروتينات، اللبنات الأساسية للخلايا، مصنوعة من الأحماض الأمينية "يسرى". ولكن، في الحمض النووي للميكروبات المرآة، تصبح النيوكلتيدات "يسرى" والأحماض الأمينية تصبح "يمنى". ولا يمكن أن تظهر مثل هذه الكائنات الحية الدقيقة إلا بشكل مصطنع.
ويقول: "سيكون من الصعب أو المستحيل إنشاء لقاحات فعالة ضد البكتيريا المرآة. والأخطر من ذلك أنها يمكن أن تصيب الحيوانات والنباتات، وسيكون من المستحيل تدميرها في النظام البيئي الدقيق الذي يدعمنا".
ووفقا للبروفيسور، تعود هذه المقاومة العالية للميكروبات "المرآة" إلى أن منظومة المناعة للكائنات الحية غير قادرة على التعرف عليها لأنها معتادة على البنية الطبيعية للحمض النووي. لذلك إذا دخلت مثل هذه البكتيريا إلى جسم الإنسان، فإنها يمكن أن تتكاثر بفعالية، ما يمنع التئام الجروح أو انسداد الأوعية الدموية. وفي الحالة الأخيرة، يمكن أن تؤدي العدوى بالبكتيريا المرآة إلى الإصابة بجلطة دماغية.
ويشير إلى أن مضادات الحيوية أو الفيروسات الخاصة يمكن أن تساعد في مكافحة هذه الكائنات غير العادية، لكن قد لا يكون للبشرية ما يكفي من الوقت لمثل هذه الدراسات.
ووفقا له، ستصبح مشكلة تغير المناخ أقل المشكلات خطورة إذا ظهرت البكتيريا المرآة في الوسط المحيط.

.jpg)
 هيدر.jpg)